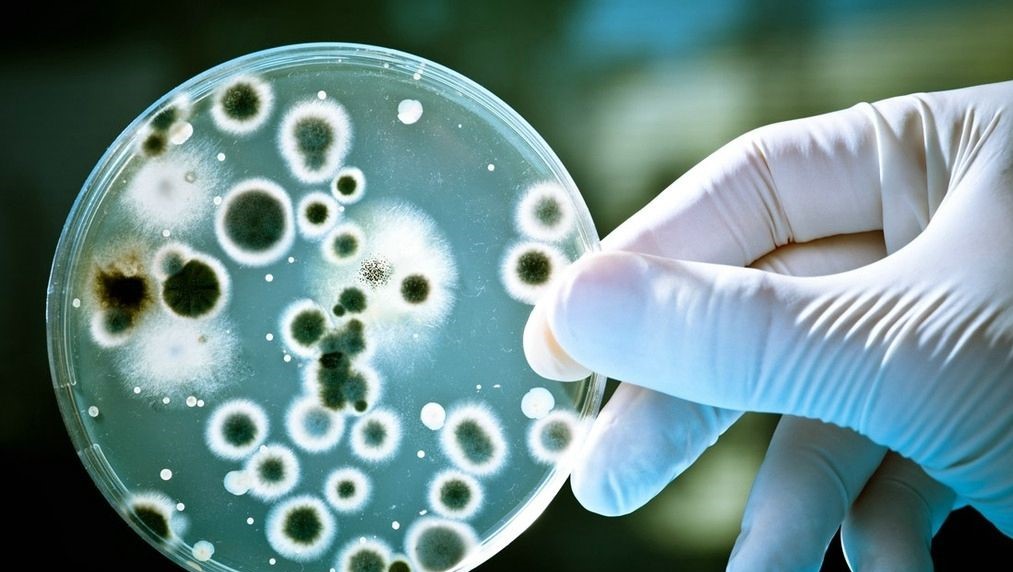
孢子丝菌病会不会危及生命,孢子丝菌病生长环境

导语:研究认为巴西孢子丝菌在人类中是嗜神经性的,它可产生大量的脲酶和黑色素,能够促进组织渗透和逃避免疫系统的毒力因子,并可传播到包括中枢神经系统在内的不同器官。孢子丝菌病的免疫机制包括两方面的因素,一是真菌的致病毒力,二是宿主的免疫反应。目前抗真菌疫苗的研制还在进行种,在研制过程中也存在很多的问题。
一、深入了解孢子丝菌的致病毒力,孢子丝菌在人类患者中是嗜神经性的
真菌的毒力因素包括双相型、耐热性、黑素、蛋白酶和细胞壁成分等。不同的孢子丝菌菌种致病毒力不同。巴西孢子丝菌毒性强,还有实验证明巴西孢子丝菌在机体内还有增加毒力的能力,球形孢子丝菌的毒力弱。
1、双相型转化
1961年,霍华德首次描述了孢子丝菌的双相型转变。孢子丝菌是双相真菌,在自然环境下为菌丝相,感染机体后转变为酵母相。环境的变化,如水分、pH、温度、营养素、氧利用率、G蛋白和钙摄取量等都可影响孢子丝菌的双相型转变;针对环境变化,真菌改变其生理和形态,以适应新的生理条件和逃避宿主的免疫反应。
这种双相型转变,对其生命周期不是必需的,但与其致病性有关。孢子丝菌病的组织病理学研究显示,多形核中性粒细胞在炎性肉芽肿的形成中有着重要的作用,为了研究PMNs与孢子丝菌的相互作用,研究者将PMNs与孢子丝菌的分生孢子或酵母细胞共同培养,通过扫描电镜(SEM)分析,认为PMNs并不影响酵母细胞核和分生孢子的活性,但可以吞噬孢子丝菌,并使其发生双相型转化。
2、耐热性
并不是所有的从环境分离的孢子丝菌菌株都可以适应宿主的温度。有学者研究发现,在哥伦比亚分离的菌株,耐热性差,临床表现以固定型多见;相反,墨西哥分离的菌株有较高的耐热性,临床表现以淋巴管多见。目前,菌株耐热性相关的因素仍不十分清楚,可能和孢子丝菌菌种和临床表现都有相关性。

3、黑素
黑素是具有不同分子结构的大分子聚合物,通常具有黑色或深褐色的颜色,由酚或吲哚化合物的氧化聚合形成。在真菌中,黑素在细胞质中合成,并沉积在细胞壁中或作为细胞外聚合物排出。
这些色素对真菌的生长和发育不是必需的。现研究认为黑素通过保护真菌免受宿主防御反应、氧化剂和水解酶,并减少吞噬作用或诱导细胞死亡的作用。研究认为黑素对孢子丝菌有保护作用,特别是抗真菌药物处在较低浓度时。
4、蛋白酶
研究表明申克孢子丝菌酵母相对宿主上皮细胞的损伤可能是由丝氨酸和天冬氨酸蛋白酶、酸性磷酸酶、胶原酶等蛋白酶的作用介导的,所有这些蛋白酶都在孢子丝菌复合物的致病毒力中起重要作用。蛋白酶的存在可能因孢子丝菌毒力不同而有所差异。有学者探讨了孢子丝菌蛋白水解酶与宿主上皮细胞间的作用。
在上皮细胞-蛋白酶相互作用期间,细胞在微丝分布以及质膜结构中显示出改变,酵母细胞具有较高的细胞内和细胞外蛋白水解活性,该研究为了解宿主-真菌相互作用以及寻找一种新的有效的抗真菌疗法(包括蛋白酶*制剂抑**)提供了重要的支持。

5、细胞结构
申克孢子丝菌复合物的毒力也归因于与宿主相互作用的某些细胞成分的存在,如细胞表面的粘附素增加了对上皮细胞和细胞外基质的粘附。孢子丝菌细胞壁成分是免疫反应的主要诱导抗原,免疫优势的60kDa糖蛋白(Gp60)已被证明与这种真菌的毒力有关,但它的具体作用尚需进一步研究。
有研究认为巴西孢子丝菌和申克孢子丝菌具有相似的细胞壁成分,其成分随细胞形态的变化而变化。这些细胞壁组成的差异,可能会影响免疫受体,进而影响细胞因子的产生。真菌释放细胞外小泡,可与宿主细胞相互作用,调节宿主的免疫反应。在体外培养条件下,从巴西孢子丝菌分离的EVs可诱导树突细胞吞噬指数和真菌负荷增加,对宿主免疫系统的毒力和调节具有重要作用。
6、环境对毒力因素的影响
物理环境包括温度、湿度、阳光、紫外线照射、生存环境的化学污染、与其共生的微生物等均会对包括申克孢子丝菌的微生物造成影响。2019年有学者认为真菌的毒力与同一环境有机体的相互作用有关,评估了巴西孢子丝菌和申克孢子丝菌与Pantoeaagglomerans(一种细菌团块)存在或不存在时的情况。
研究认为真菌能够利用杀灭的细菌作为碳源和氮源进行生长;也有研究说明当真菌与铜绿假单胞菌、肺炎克雷伯菌等细菌接触时,可以促进黑素的生物合成,这些发现有助于更好地了解孢子丝菌的生态学和毒力。

二、了解宿主免疫的相关机制,宿主免疫可以分为固有免疫和获得性免疫
宿主免疫分为固有免疫和获得性免疫,固有免疫包括天然的皮肤粘膜屏障,固有免疫细胞及固有免疫因子。孢子丝菌缺乏高效的能穿透表皮细胞的酶,所以完整的皮肤粘膜屏障可起到预防孢子丝菌的作用。天然的免疫细胞主要包括巨噬细胞、中性粒细胞、树突状细胞;天然的免疫因子包括补体、活性氧簇、细胞因子等,具有快速识别并杀灭病原体的能力。
1、天然免疫
孢子丝菌侵入组织后,为适应宿主环境的变化,会转变为致病的酵母相。细胞免疫是参与孢子丝菌感染后的主要免疫,天然免疫细胞发挥着巨大的作用,巨噬细胞和树突状细胞除了直接杀灭病原体外,还承担着抗原呈递的重要作用。
Toll样受体是巨噬细胞重要的模式识别受体,可释放出一系列的细胞因子参与细胞免疫的过程。TLR-2在免疫应答开始时的重要性,受体刺激后促进了TNF-α、IL-12、IL-1β、IL-10、IFN-γ、IL-6、IL-17和TGF-β以及一氧化氮等细胞因子产生,这些细胞因子与T淋巴细胞分化为Th1和Th17细胞以及调节特异性抗真菌反应中的效应器功能有关。
树突状细胞可根据抗原的识别和数量调节对真菌的炎症反应。研究表明,高浓度的抗原可能刺激细胞因子IL-23、IL-6、TGF-β和IL-17的表达,从而导致T细胞在体外分化为Th1和Th17,这表明不同的初始刺激量可能诱导不同的免疫反应。
中性粒细胞能够最早(6h左右)趋化聚集于感染部位,但是中性粒细胞的*伤杀**效率低,无法独立消灭真菌,其主要作用可能是早期控制感染并参与启动免疫反应,趋化其他免疫细胞进入感染部位。宿主免疫应答包括多形核中性粒细胞趋化和颗粒成分的释放。

乳铁蛋白是铁结合蛋白转铁蛋白家族中的一个蛋白质成员,存在于多形核颗粒结构中,应用免疫组化法检测乳铁蛋白,酵母细胞周围乳铁蛋白免疫染色均为阳性,研究认为乳铁蛋白可阻止真菌在皮肤孢子丝菌病中的发育和增殖。
NK细胞是除T细胞、B细胞之外的第三大类淋巴细胞,属于天然免疫系统的核心细胞,主要分布于外周血、肝脏和脾脏,约占血液中所有免疫细胞的15%。除了具有强大的*伤杀**功能外,还具有很强的免疫调节功能,与机体其他多种免疫细胞相互作用,调节机体的免疫功能。然而,目前我们对真菌感染背景下NK细胞的发育、成熟和激活的了解只是初步的。
2、获得性免疫
巨噬细胞被特异性T细胞介导的免疫反应激活后产生以Th表型为特征的细胞因子,从而杀灭多种病原体。Th是适应性免疫反应的重要调控因子,可细分为越来越多的亚群。Th1、Th2以及Th17型细胞免疫反应在小鼠体内或体外进行过很多抗真菌作用的研究。
体外和体内研究都表明,对孢子丝菌的适应性免疫反应是Th1/Th17混合型,Th17和Th1/Th17混合型细胞比Th1型细胞占优势。体液免疫也属于获得性免疫,细胞免疫在孢子丝菌免疫机制中发挥着重要的作用,但体液免疫的作用也不可忽视。
Th2反应开始于第5周,提示体液免疫反应只参与孢子丝菌病的晚期,IL-4和IL-10水平升高,但有研究发现这一过程可能反过来抑制Th1反应。有研究提出用二维凝胶电泳进行大规模的蛋白质组分析,可研究孢子丝菌病体液反应。

三、抗感染疫苗的研究成为一个新兴领域,亚单位疫苗易于制造和标准化
孢子丝菌病在世界范围内发生,是一种重要的人畜共患病。孢子丝菌病是报道最多的皮下真菌病,由于目前可用于治疗真菌感染的选择有限,抗孢子丝菌疫苗的开发已成为一个新兴领域。近年来,对申克孢子丝菌细胞壁的免疫活性成分的研究已成为世界范围内流行的防治疫苗的相关靶点。
巨噬细胞在抵抗真菌感染的第一道防线中发挥重要的作用,除了可直接吞噬真菌,研究还发现通过PRRs的免疫调节单核细胞和/或巨噬细胞中的配体可以提供抗真菌药物保护性免疫。这个新策略,用于产生广谱抗感染的方法,被命名为训练免疫疫苗策略。
疫苗研究的热点主要包括真菌的细胞壁成分、重组蛋白及免疫佐剂、合成蛋白等。一般来说,抗感染疫苗的抗原可以是不同类型,包括灭活或减弱的全细胞或亚单位抗原,技术可使用重组和合成技术。
整个失活的生物体都有复杂的化学成分,这使得制造和标准化变得困难。另一方面,减弱的真菌,尽管具有很强的免疫原性,但不能用于免疫功能低下的病人。亚单位疫苗更安全,易于制造和标准化,但是它们的免疫原性很差,需含有提高免疫原性和疗效的佐剂。

结语:从近几年疫苗的研究趋势来看,巴西是研究最多的国家。前面流行病学已经提出人畜共患的孢子丝菌病在巴西流行的范围越来越广,发病率越来越高,已上升为公共卫生问题,这是巴西在孢子丝菌病疫苗方面研究及投入较多的原因。免疫低下的患者是否可以引起免疫应答,以及基因组的变异和不同地区致病菌的差别,都影响着孢子丝菌病疫苗的开发及研制。